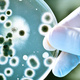
Microaguas

-
Explica que la sífilis es provocada por un microorganismo imperceptible.
Explica los diferentes métodos de contagio.
Escribió dos obras acerca de la sífilis: Syphilidis sive de morbo gallico libri tres y De contagione et contagiosis morbis.
Propuso la teoría de que las enfermedades son causadas por gérmenes.
"No puedo comprobar la existencia de los microorganismos por no tener microscopios." -
Produjo observaciones con microscopio compuesto
Describió hongos filamentosos (1667) y la estructura celular de plantas (1665) -
Demostró la falsedad de la teoría de la generación espontánea a nivel macroscópico, particularmente el hecho de que los gusanos en la carne podrida no se originaban sólo porque sí, sino mediante huevos de moscas depositados en dicho alimento.
-
Demostró la existencia de microorganismos mediante la observación a través de un microscopio fabricado por él.
Envió alrededor de 375 observaciones a la Royal Society de Londres y 27 a la Académie Royal des Sciences de París. -
Destrucción de organismos preexistentes en la carne a través de la ebullición.
-
Investigó acerca de la regeneración y observó que los individuos jóvenes tienen mayor capacidad de regeneración que los adultos de una misma especie y que son las partes superficiales del cuerpo las que se pueden regenerar.
Trabajó en trasplantes y logró trasplantar una cabeza de caracol en el cuerpo de otro. -
Demostró la falsedad de la teoría de la generación espontánea a nivel microscópico (los microbios provienen de microbios).
-
Investigó sobre la circulación de la sangre a través de los pulmones y otros órganos y realizó importantes experimentos acerca de la digestión, obteniendo así evidencia de que el jugo gástrico contiene sustancias químicas especiales que se adaptan a distintos alimentos.
-
Vacuna contra la viruela
-
Padre de la epidemiología moderna. Realiza el primer estudio epidemiológico del cólera en Londres
-
Demostró la falsedad del argumento de Pouchet acerca de la generación espontánea
Demuestra que los diferentes tipos de bacterias tienen actividad biológica sin necesidad de cultivos diferentes
Algunos microbios pueden vivir sin oxígeno.
Esterilización con vapor a presión.
1864 Desarrolla el método conocido como pasteurización.
Descubrió que los microorganismos causan fermentación y enfermedades.
Salvó industrias de cerveza, vino y seda.
1881 y 1885 Desarrolló vacunas contra el ántrax y la rabia. -
Demuestra que los microbios acompañan a partículas de polvo en el aire y son de tipo termoestable.
-
Observa el ciclo de esporulación de bacillus anthracis (causa del carbunco).
Métodos de cultivo puro utilizando medios sólidos.
Perfecciona las técnicas de tinción de bacterias.
Descubre el bacilo tuberculoso y la hipersensibilidad tardía a la tuberculina.
Establece cuatro condiciones para asegurar la categoría de agentes causantes de enfermedades infecciosas.
Gana el premio Nobel. -
Introduce la práctica de cirugía antiséptica.
Obtiene los primeros cultivos puros de bacterias y establece el método de extinción por dilución. -
Entre 1878 y 1881 trabajó al lado de Pasteur desarrollando métodos para preparar vacunas para cólera, ántrax y rabia.
Demostró que la difteria era causada por una toxina -
Introduce el concepto de que la inmunidad celular antimicrobiana es realizada por fagocitos.
-
Desarrollo del método de tinción de Gram
-
Descubridor de la brucelosis y enfermedades tropicales
-
Descubrimiento de la la Babesia bigemina, el parásito protozoo transmitido por la garrapata que es responsable de la fiebre de Texas; junto con el veterinario F. L. Kilbourne.
-
Pionero de la inmunología y descubridor de las vacunas contra el tétano y la difteria.
-
Descubrió el ciclo vital del parásito de la malaria en el mosquito Anopheles. Gracias a este descubrimiento fue galardonado en 1902 con el Premio Nobel de Fisiología y Medicina.
-
Método para estandarizar toxinas y antitoxinas.
Crea el método de tinción ácido resistente
Establece la teoría de la producción de anticuerpos
Introduce la quimioterapia -
Su contribución más importante fue sin dudas su demostración de que el mosquito transporta, vía su sistema digestivo, el Plasmodium responsable del paludismo.
-
Demostró que la fiebre amarilla es transmitida por picaduras de mosquitos infectados.
-
Descubrimiento del agente bacteriológico lisozima.
1928- Descubre la penicilina
Want to make a timeline like this?
Use Timetoast to turn dates, events, milestones, and phases into a clear visual timeline you can build and share. Timetoast is a timeline maker for work, school, research, and stories.